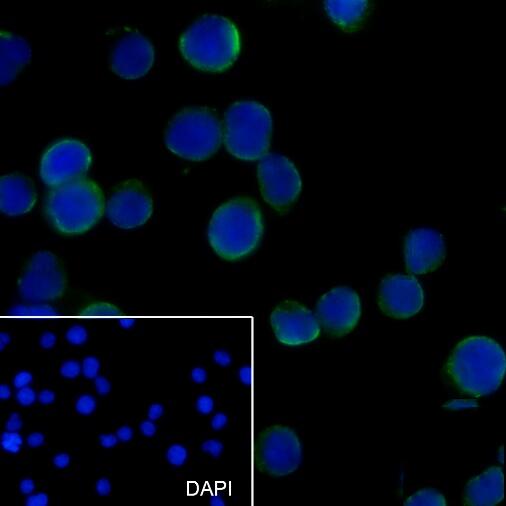

CD89 Mouse mAb
产品介绍
Binds to the Fc region of immunoglobulins alpha. Mediates several functions including cytokine production.
产品性质
产品特色
推荐稀释比 ICC/IF:1/50;FC:1/50-1/100
应用案例
Immunocytochemistry analysis of CD89(green) in Jurkat cells using CD89 antibody,and DAPI(blue).

Flow Cytometry analysis of PBMC stained with CD89 antibody(Red).Blue line histogram represents nonspecific negative control
存储条件
Store at 4°C short term. Aliquot and store at -20°C long term. Avoid freeze/thaw cycles.
COA
联系我们
